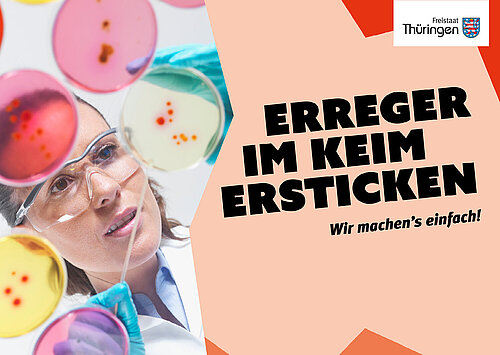
Kampagnenmotiv "Erreger im Keim ersticken"

Hygiene in Einrichtungen - Infektionen vermeiden
Hier finden Einrichtungen, über die der ÖGD die infektionshygienische Aufsicht hat, Informationen, Formulare, Muster-Hygienepläne und ähnliches. Zu den Einrichtungen gehören beispielsweise
Schulen und Kitas,
Krankenhäuser und Arztpraxen,
Pflegeeinrichtungen,
Asylunterkünfte und Justizvollzugsanstalten sowie
Friseursalons und Tattoostudios.
Diese Arbeitshilfen wurden überwiegend vom Thüringer Landesamt für Verbraucherschutz (TLV) und vom Thüringer Landesverwaltungsamt (TLVwA) erstellt. Sie sollen die Zusammenarbeit mit den ÖGD-Behörden, hier insbesondere den 22 Thüringer Gesundheitsämtern, unterstützen und die betroffenen Einrichtungen entlasten.
Bei Nachfragen wenden Sie sich gerne über den Kontakt dieses Fachportals an uns oder direkt an Ihr zuständiges Gesundheitsamt das TLV oder das TLVwA.
Infektionsschutz
Wir schützen die Menschen in Thüringen vor Infektionskrankheiten und entwickeln wirksame Vorsorgekonzepte zur Verhütung und Bekämpfung übertragbarer Krankheiten .
Auf den Seiten des Thüringer Landesamts für Verbraucherschutz finden Sie für Einrichtungen zahlreiche weiterführende Informationen, wie relevante Publikationen, Checklisten und Formulare.
Häufig nachgefragte Themen sind beispielsweise
Kopfläuse
Leitfäden für das Management von Masern- und Keuchhustenfällen
Krätzmilbenbefall (Skabies) in Gemeinschaftseinrichtungen
Postexpositionsprophylaxe bei Kontakt zu Erkrankten mit Haemophilus influenzae b- bzw. Meningokokken-Infektion
Arztmeldeformular über eine meldepflichtige Krankheit
Erregerübersicht und Labormeldeformular über den Nachweis von Krankheitserregern
Multiresistente Erreger
Der Schutz vor und der Umgang mit sogenannten Multiresistenten Erregern (MRE) ist eine wichtige Herausforderung für medizinische Einrichtungen. MRE sind bestimmte Bakterienstämme, die auf die gängigen Antibiotika nicht mehr ansprechen.
Das MRE-Netzwerk Thüringen wurde gegründet, um Fachwissen zu bündeln und Verantwortliche zu unterstützen. Es verbindet die regionalen Netzwerke der Thüringer Stadt- und Landkreise. Die Plattform stellt fachliche Informationen, Formulare und Hilfen zur Dokumentation für folgende Einrichtungen und Personengruppen bereit:
Patienten und Angehörige
Krankenhäuser
stationäre Rehabilitationseinrichtungen
stationäre Pflege- und Betreuungseinrichtungen
ambulante medizinische und pflegerische Einrichtungen
Tagespflege
Behinderteneinrichtungen
ambulante bzw. häusliche Krankenpflege
Rettungs- und Krankentransportdienste
Bei konkreten Fragestellungen wenden Sie sich bitte an Ihr zuständiges regionales MRE-Netzwerk bzw. Gesundheitsamt.
Rahmenhygienepläne für medizinische und nichtmedizinische Einrichtungen
Bestimmte medizinische und nicht-medizinische Einrichtungen werden durch unsere Gesundheitsämter infektionshygienisch überwacht. Gemeinschafts- und Gesundheitseinrichtungen müssen in Thüringen auf Basis des Infektionsschutzgesetzes (IfSG) oder der Thüringer Verordnung über die Hygiene und Infektionsprävention in medizinischen Einrichtungen und zur Übertragung einer Ermächtigung nach dem Infektionsschutzgesetz (ThürmedHygVO) Hygienepläne erstellen.
Die Rahmenhygienepläne für diese medizinischen und nicht-medizinischen Einrichtungen finden Sie auf den Seiten des Thüringer Landesamtes für Verbraucherschutz.
Nicht-medizinische Einrichtungen:
Kindertagesstätten
Schulen
Einrichtungen der Kinder- und Jugendhilfe (z.B. Kinderheime)
Ferienlager und ähnliche Einrichtungen
Tattoo- und Piercingstudios
Kosmetikstudios, Fußpflegeeinrichtungen, u.a.
Obdachlosenunterkünfte
Asylunterkünfte
Sportstätten, u.a.
Medizinische Einrichtungen:
Krankenhäuser
Alten- und Pflegeheime sowie andere Einrichtungen nach § 1 Heimgesetz
Einrichtungen für ambulantes Operieren
Vorsorge- und Rehabilitationseinrichtungen
Dialyseeinrichtungen
Ambulante Pflegedienste
Entbindungseinrichtungen
Rettungs- und Krankentransportdienste
medizinische Fußpflege (Podologie)
Krankenhaushygienische Untersuchungen

Klare Abläufe und eine lückenlose Dokumentation sind in der Krankenhaushygiene essenziell. Im Krankenhaushygienelabor des Thüringer Landesamtes für Verbraucherschutz (TLV) werden hygienisch-mikrobiologische Untersuchungen durchgeführt.
Das Labor ist nach DIN EN ISO 17025 akkreditiert. Das Untersuchungsangebot umfasst verschieden Methoden, unter anderem Prüfung von Reinigungs-, Desinfektions- und Sterilisationsverfahren mittels Bioindikatoren sowie Umgebungsuntersuchungen mittels Tupfer, Abklatsch- und Sedimentationsplatten.
Für die Beauftragung einer Untersuchung stehen Auftrags- und Erfassungsscheine sowie Hinweise zur Testdurchführung für Sie bereit.
Laden Sie hier die benötigten Formulare herunter:

